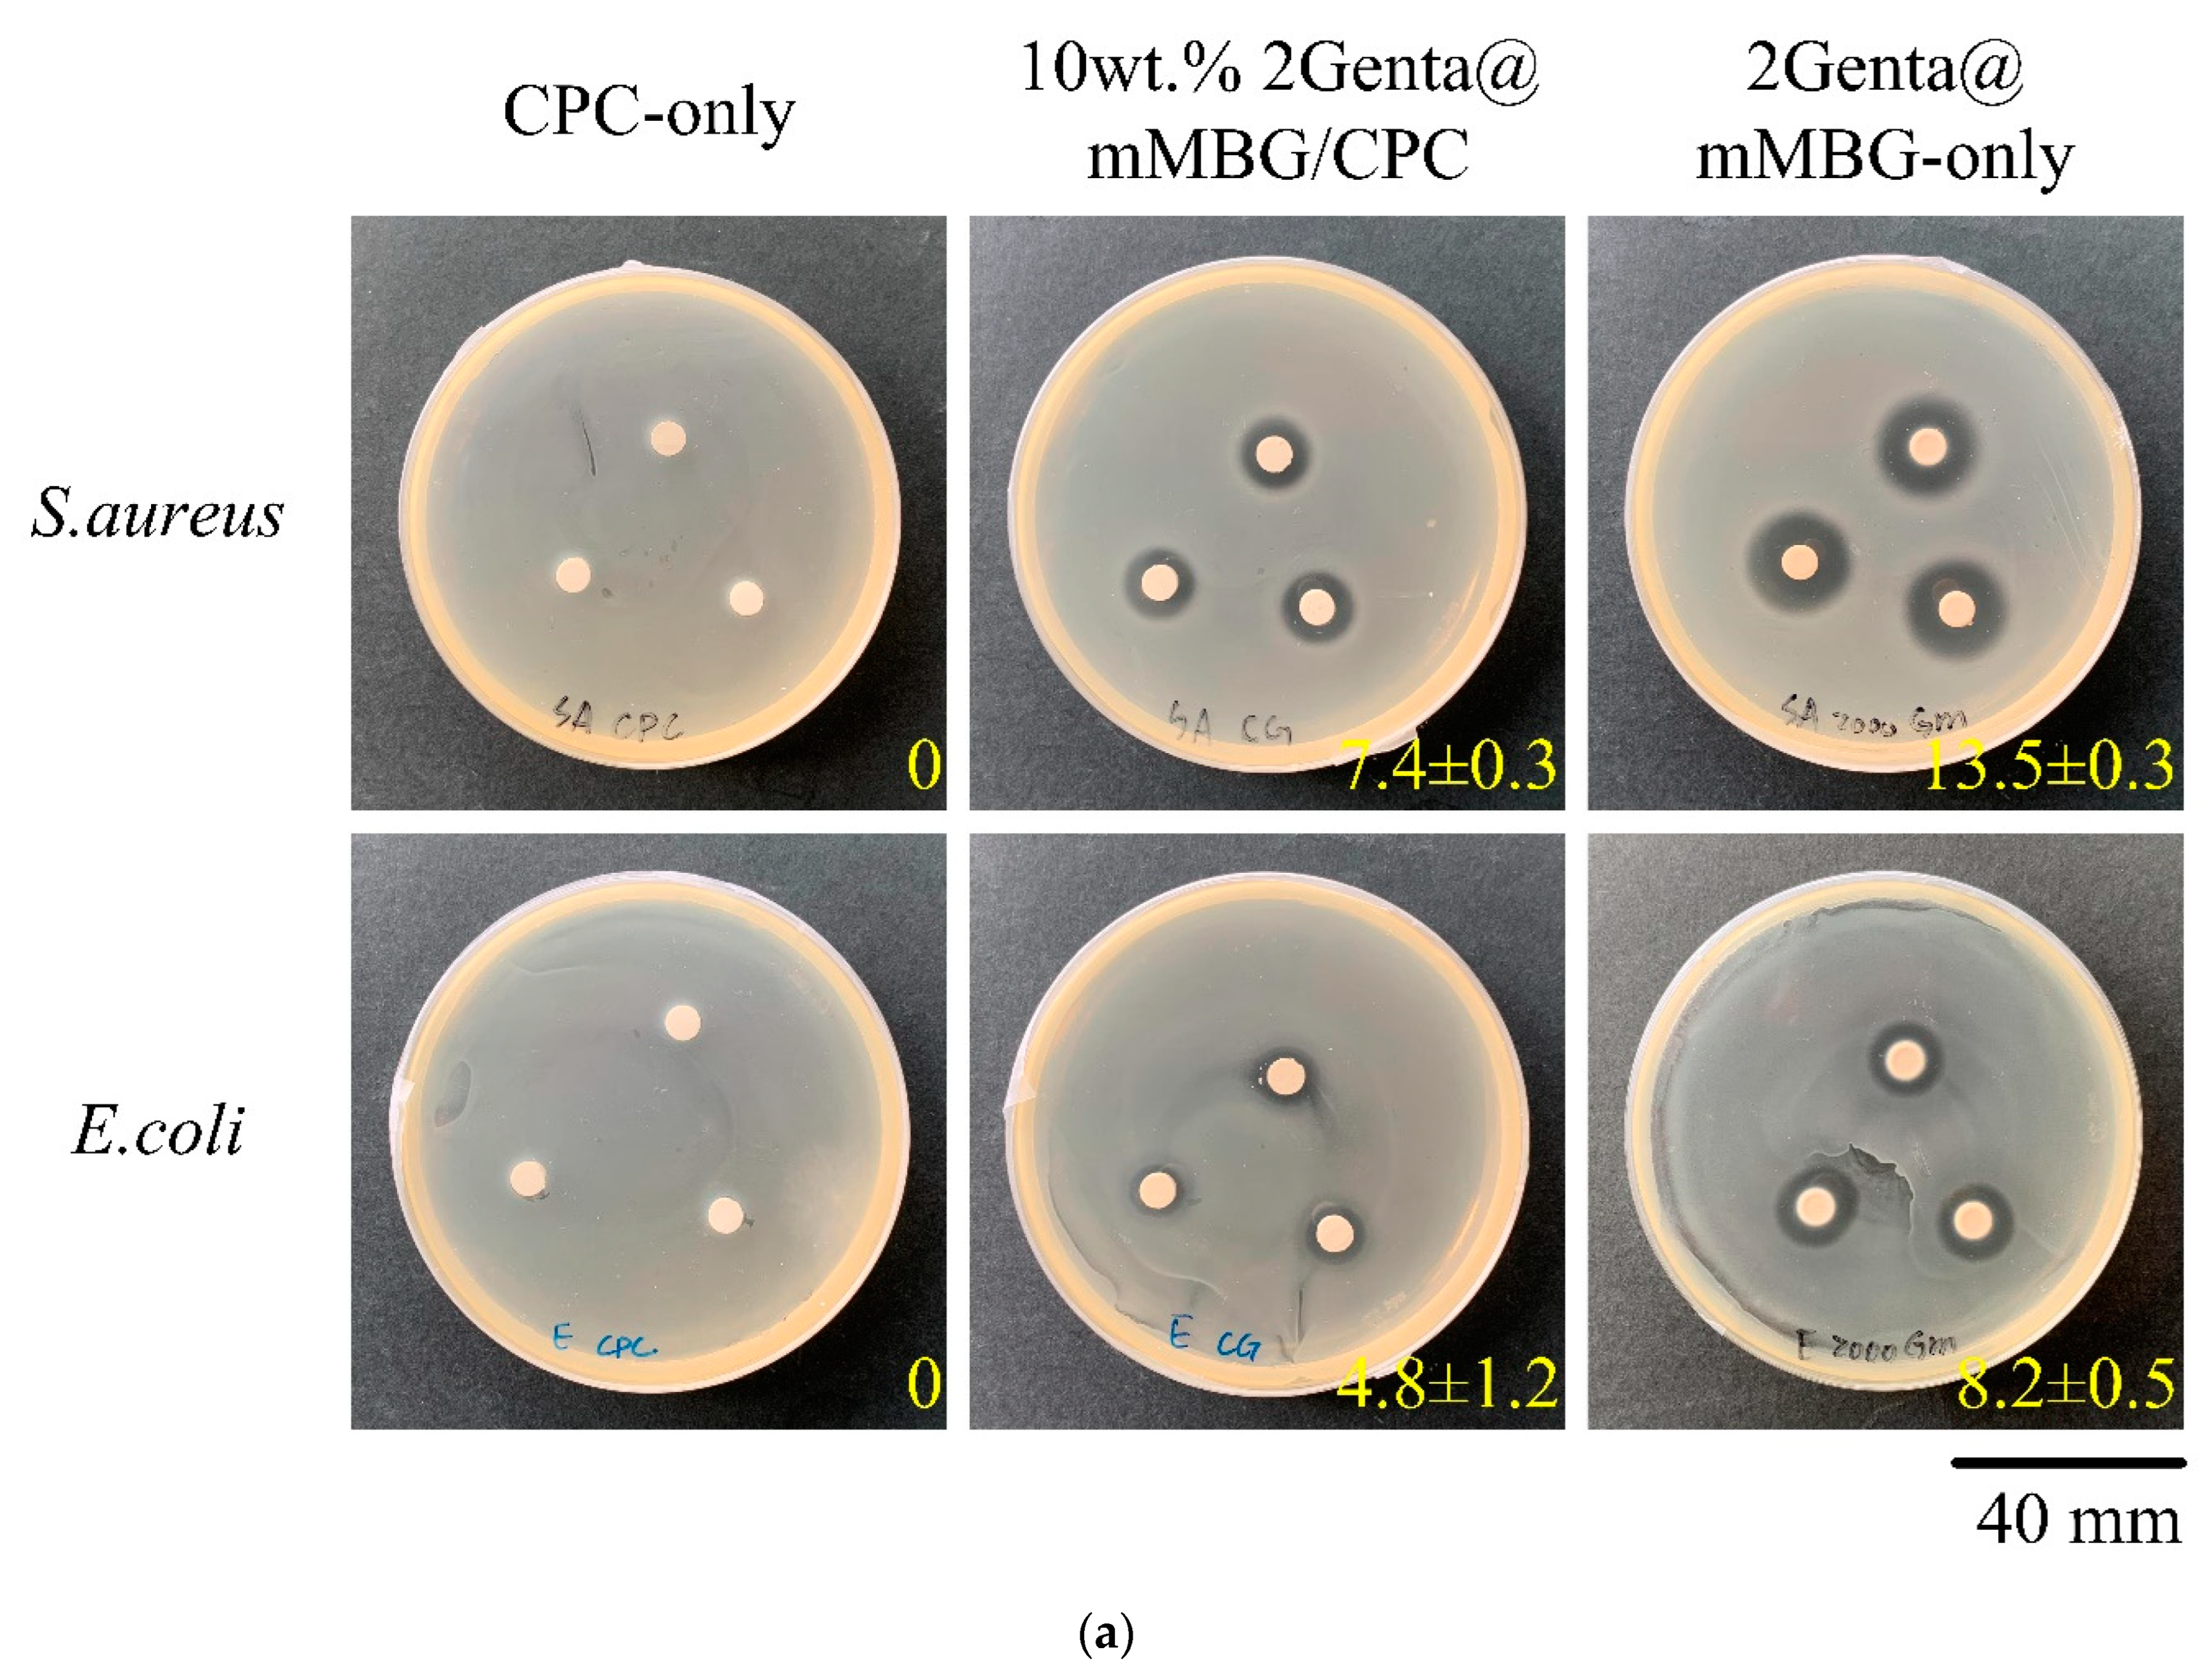
Biomimetics 07 00121 g007a

Injectability, Processability, Drug Loading, and Antibacterial Activity of Gentamicin-Impregnated Mesoporous Bioactive Glass Composite Calcium Phosphate Bone Cement In Vitro
Abstract
:1. Introduction
2. Materials and Methods
2.1. Raw Materials
2.2. Preparations of CPC, mMBG, Genta@mMBG, and mMBG/CPC Composite Bone Cements
2.2.1. CPC Preparation
2.2.2. MBG Micro-Powder and Antibiotic-Impregnated mMBG (Genta@mMBG)
2.2.3. mMBG/CPC and 2Genta@mMBG/CPC Composite Bone Cement
2.3. Characterization of MBG and Antibiotic Impregnated Genta@mMBG
2.4. Characterization of mMBG/CPC and Genta@mMBG/CPC Composite Bone Cements
2.4.1. X-ray Diffraction (XRD) and Fourier Transform Infrared Spectroscopy (FTIR) Analysis
2.4.2. Working/Setting Time, Injectability, and Dispersibility
2.4.3. Compressive Strength and Fracture Surface Observation
2.5. Antibacterial Abilities
2.6. In Vitro Cytotoxicity Tests
2.7. Statistical Analysis
3. Results and Discussion
3.1. Characterization of Genta@mMBG/CPC Composite
3.1.1. Injectability, Dispersibility, and Working/Setting Time of Genta@mMBG/CPC Composite
3.1.2. Working/Setting Time, Compressive Strength, and Fracture Surface Observation of GentaM/CPC Composite
3.2. Characterization of mMBG and Genta-Impregnated mMBG
3.2.1. Antibacterial Abilities of mMBG and Genta@mMBG
3.2.2. SEM, TEM, and BET of MBG and Genta-Impregnated mMBG
3.3. Characterization of mMBG/CPC and Genta@mMBG/CPC Composites
3.3.1. FTIR and XRD of mMBG/CPC and Genta@mMBG/CPC Composites
3.3.2. Antibacterial Abilities of Genta@mMBG/CPC Composite
3.3.3. Cytotoxicity of mMBG and Antibiotic-Impregnated 2Genta@mMBG and mMBG/CPC Composites
4. Conclusions
Author Contributions
Funding
Institutional Review Board Statement
Informed Consent Statement
Data Availability Statement
Acknowledgments
Conflicts of Interest
References
- Brown, W. A new calcium phosphate setting cement. J. Dent. Res. 1983, 62, 672. [Google Scholar]
- Zhong, W.; Sun, L.; Yu, T.; Zhou, C. Preparation and characterization of calcium phosphate cement with enhanced tissue adhesion for bone defect repair. Ceram. Int. 2021, 47, 1712–1720. [Google Scholar] [CrossRef]
- Di Filippo, M.F.; Giuri, D.; Marchiori, G.; Maglio, M.; Pagani, S.; Fini, M.; Tomasini, C.; Panzavolta, S. Self-assembling of fibers inside an injectable calcium phosphate bone cement: A feasibility study. Mater. Today Chem. 2022, 24, 100991. [Google Scholar] [CrossRef]
- Ko, C.-L.; Chen, J.-C.; Hung, C.-C.; Wang, J.-C.; Tien, Y.-C.; Chen, W.-C. Biphasic products of dicalcium phosphate-rich cement with injectability and nondispersibility. Mater. Sci. Eng. C 2014, 39, 40–46. [Google Scholar] [CrossRef] [PubMed]
- Cai, Z.; Wu, Z.; Wan, Y.; Yu, T.; Zhou, C. Manipulation of the degradation behavior of calcium phosphate and calcium sulfate bone cement system by the addition of micro-nano calcium phosphate. Ceram. Int. 2021, 47, 29213–29224. [Google Scholar] [CrossRef]
- Amirian, J.; Makkar, P.; Lee, G.H.; Paul, K.; Lee, B.T. Incorporation of alginate-hyaluronic acid microbeads in injectable calcium phosphate cement for improved bone regeneration. Mater. Lett. 2020, 272, 127830. [Google Scholar] [CrossRef]
- Dolci, L.S.; Panzavolta, S.; Torricelli, P.; Albertini, B.; Sicuro, L.; Fini, M.; Bigi, A.; Passerini, N. Modulation of Alendronate release from a calcium phosphate bone cement: An in vitro osteoblast-osteoclast co-culture study. Int. J. Pharm. 2019, 554, 245–255. [Google Scholar] [CrossRef]
- Liu, S.-M.; Chen, W.-C.; Ko, C.-L.; Chang, H.-T.; Chen, Y.-S.; Haung, S.-M.; Chang, K.-C.; Chen, J.-C. In vitro evaluation of calcium phosphate bone cement composite hydrogel beads of cross-linked gelatin-alginate with gentamicin-impregnated porous scaffold. Pharmaceuticals 2021, 14, 1000. [Google Scholar] [CrossRef]
- Lalzawmliana, V.; Anand, A.; Roy, M.; Kundu, B.; Nandi, S.K. Mesoporous bioactive glasses for bone healing and biomolecules delivery. Mater. Sci. Eng. C 2020, 106, 110180. [Google Scholar] [CrossRef]
- Chang, Y.; Zhao, R.; Wang, H.; Pang, L.; Ding, J.; Shen, Y.; Guo, Y.; Wang, D. A novel injectable whitlockite-containing borosilicate bioactive glass cement for bone repair. J. Non-Cryst. Solids 2020, 547, 120291. [Google Scholar] [CrossRef]
- Thaitalay, P.; Giannasi, C.; Niada, S.; Thongsri, O.; Dangviriyakul, R.; Srisuwan, S.; Suksaweang, S.; Brini, A.T.; Rattanachan, S.T. Nano-bioactive glass incorporated polymeric apatite/tricalcium phosphate cement composite supports proliferation and osteogenic differentiation of human adipose-derived stem/stromal cells. Mater. Today Commun. 2022, 31, 103590. [Google Scholar] [CrossRef]
- Richter, R.F.; Ahlfeld, T.; Gelinsky, M.; Lode, A. Composites consisting of calcium phosphate cements and mesoporous bioactive glasses as a 3D plottable drug delivery system. Acta Biomater. 2022. [Google Scholar] [CrossRef] [PubMed]
- Gupta, S.; Majumdar, S.; Krishnamurthy, S. Bioactive glass: A multifunctional delivery system. J. Control. Release 2021, 335, 481–497. [Google Scholar] [CrossRef] [PubMed]
- Zheng, K.; Boccaccini, A.R. Sol-gel processing of bioactive glass nanoparticles: A review. Adv. Colloid Interface Sci. 2017, 249, 363–373. [Google Scholar] [CrossRef]
- Lin, J.; Liu, L.; Huang, S.; Zheng, W.; Liu, H.; Bai, Z.; Jiang, K.; Wang, X. PCL nanofibrous incorporating unique matrix fusion protein adsorbed mesoporous bioactive glass for bone tissue engineering. Int. J. Biol. Macromol. 2022, 208, 136–148. [Google Scholar] [CrossRef]
- Demir-Oğuz, Ö.; Boccaccini, A.R.; Loca, D. Injectable bone cements: What benefits the combination of calcium phosphates and bioactive glasses could bring? Bioact. Mater. 2022, 19, 217–236. [Google Scholar] [CrossRef]
- Mabroum, H.; Noukrati, H.; Ben youcef, H.; Oudadesse, H.; Barroug, A. The effect of bioactive glass particle size and liquid phase on the physical-chemical and mechanical properties of carbonated apatite cement. Ceram. Int. 2022, 48, 28207–28220. [Google Scholar] [CrossRef]
- Ruan, Z.; Yao, D.; Xu, Q.; Liu, L.; Tian, Z.; Zhu, Y. Effects of mesoporous bioglass on physicochemical and biological properties of calcium sulfate bone cements. Appl. Mater. Today 2017, 9, 612–621. [Google Scholar] [CrossRef]
- David Chen, C.-H.; Chen, C.-C.; Shie, M.-Y.; Huang, C.-H.; Ding, S.-J. Controlled release of gentamicin from calcium phosphate/alginate bone cement. Mater. Sci. Eng. C 2011, 31, 334–341. [Google Scholar] [CrossRef]
- Koh, B.T.; Tan, J.; Ramruttun, A.K.; Wang, W. Effect of storage temperature and equilibration time on polymethyl methacrylate (PMMA) bone cement polymerization in joint replacement surgery. J. Orthop. Surg. Res. 2015, 10, 1–6. [Google Scholar] [CrossRef]
- He, Z.; Zhai, Q.; Hu, M.; Cao, C.; Wang, J.; Yang, H.; Li, B. Bone cements for percutaneous vertebroplasty and balloon kyphoplasty: Current status and future developments. J. Orthop. Transl. 2015, 3, 1–11. [Google Scholar] [CrossRef] [PubMed] [Green Version]
- Schoenfeld, C.; Lautenschlager, E.; Meyer, P. Mechanical properties of human cancellous bone in the femoral head. Med. Biol. Eng. 1974, 12, 313–317. [Google Scholar] [CrossRef] [PubMed]
- Misch, C.E.; Qu, Z.; Bidez, M.W. Mechanical properties of trabecular bone in the human mandible: Implications for dental implant treatment planning and surgical placement. J. Oral Maxillofac. Surg. 1999, 57, 700–706. [Google Scholar] [CrossRef]
- Tony, M.K.; Elise, F.; Oscar, C. Bone Mechanics in Standard Handbook of Biomedical Engineering and Design; McGraw Hill: New York, NY, USA, 2004. [Google Scholar]
- Sudipta; Mishra, S.; Murugavel, S. Biomineralization behavior of ternary mesoporous bioactive glasses stabilized through ethanol extraction process. J. Non-Cryst. Solids 2022, 589, 121630. [Google Scholar] [CrossRef]
- Chen, Q.; Zhao, X.; Lai, W.; Li, Z.; You, D.; Yu, Z.; Li, W.; Wang, X. Surface functionalization of 3D printed Ti scaffold with Zn-containing mesoporous bioactive glass. Surf. Coat. Technol. 2022, 435, 128236. [Google Scholar] [CrossRef]
- Du, X.; Wei, D.; Huang, L.; Zhu, M.; Zhang, Y.; Zhu, Y. 3D printing of mesoporous bioactive glass/silk fibroin composite scaffolds for bone tissue engineering. Mater. Sci. Eng. C 2019, 103, 109731. [Google Scholar] [CrossRef]
- Wen, C.; Qian, J.; Luo, L.; Zeng, J.; Sa, B.; Zhan, X.; Wang, J.; Sheng, L.; Zheng, Y. Effect of nitrogen on the structure evolution and biological properties of mesoporous bioactive glass nanospheres: Experiments and simulations. J. Non-Cryst. Solids 2022, 578, 121329. [Google Scholar] [CrossRef]
- You, R.; Qi, H.; Chen, C.; Xie, H. Effect of mesoporous silica@nano-bioactive glass complex particles on the durability of dentin bonding. Microporous Mesoporous Mater. 2022, 341, 112103. [Google Scholar] [CrossRef]
- Liu, Y.-Z.; Li, Y.; Yu, X.-B.; Liu, L.-N.; Zhu, Z.-A.; Guo, Y.-P. Drug delivery property, bactericidal property and cytocompatibility of magnetic mesoporous bioactive glass. Mater. Sci. Eng. C 2014, 41, 196–205. [Google Scholar] [CrossRef]
- Briceño, S.; Chavez-Chico, E.A.; González, G. Diatoms decorated with gold nanoparticles by In-situ and Ex-situ methods for in vitro gentamicin release. Mater. Sci. Eng. C 2021, 123, 112018. [Google Scholar] [CrossRef]
- Fu, P.-S.; Wang, J.-C.; Lai, P.-L.; Liu, S.-M.; Chen, Y.-S.; Chen, W.-C.; Hung, C.-C. Biodegradable Hydrogel Beads Combined with Calcium Phosphate Bone Cement for Bone Repair: In Vitro and In Vivo Characterization. Polymers 2022, 14, 505. [Google Scholar] [CrossRef] [PubMed]
- Lin, D.-J.; Lin, H.-L.; Haung, S.-M.; Liu, S.-M.; Chen, W.-C. Effect of ph on the in vitro biocompatibility of surfactant-assisted synthesis and hydrothermal precipitation of rod-shaped nano-hydroxyapatite. Polymers 2021, 13, 2994. [Google Scholar] [CrossRef] [PubMed]
- Tariq, U.; Hussain, R.; Tufail, K.; Haider, Z.; Tariq, R.; Ali, J. Injectable dicalcium phosphate bone cement prepared from biphasic calcium phosphate extracted from lamb bone. Mater. Sci. Eng. C 2019, 103, 109863. [Google Scholar] [CrossRef] [PubMed]
- Xiao, J.; Wan, Y.; Yang, Z.; Huang, Y.; Yao, F.; Luo, H. Bioactive glass nanotube scaffold with well-ordered mesoporous structure for improved bioactivity and controlled drug delivery. J. Mater. Sci. Technol. 2019, 35, 1959–1965. [Google Scholar] [CrossRef]
- Kumar, A.; Sudipta; Murugavel, S. Influence of textural characteristics on biomineralization behavior of mesoporous SiO2-P2O5-CaO bioactive glass and glass-ceramics. Mater. Chem. Phys. 2020, 242, 122511. [Google Scholar] [CrossRef]
- Chen, Y.-H.; Kung, J.-C.; Tseng, S.-P.; Chen, W.-C.; Wu, S.-M.; Shih, C.-J. Effects of AgNPs on the structure and anti-methicillin resistant Staphylococcus aureus (MRSA) properties of SiO2-CaO-P2O5 bioactive glass. J. Non-Cryst. Solids 2021, 553, 120492. [Google Scholar] [CrossRef]
- Saberi, A.; Behnamghader, A.; Aghabarari, B.; Yousefi, A.; Majda, D.; Huerta, M.V.M.; Mozafari, M. 3D direct printing of composite bone scaffolds containing polylactic acid and spray dried mesoporous bioactive glass-ceramic microparticles. Int. J. Biol. Macromol. 2022, 207, 9–22. [Google Scholar] [CrossRef]
- Shi, H.; Ye, X.; He, F.; Ye, J. Improving osteogenesis of calcium phosphate bone cement by incorporating with lysine: An in vitro study. Colloids Surf. B 2019, 177, 462–469. [Google Scholar] [CrossRef]
- ISO 10993–5: 2009; Biological Evaluation of Medical Devices—Part 5: Tests for In Vitro Cytotoxicity. International Organization for Standardization: Geneva, Switzerland, 2009.

| Samples | Working Time (min) | Setting Time (min) | Compressive Strength (MPa) |
|---|---|---|---|
| CPC-only | 9.81 ± 0.33 | 13.42 ± 0.66 | 75.40 ± 9.12 |
| 5 wt.% mMBG/CPC composite bone cement | 7.62 ± 0.19 * | 11.37 ± 0.65 * | 70.32 ± 9.57 |
| 10 wt.% mMBG/CPC composite bone cement | 5.24 ± 0.47 * | 9.59 ± 0.42 * | 50.97 ± 8.36 * |
| 15 wt.% mMBG/CPC composite bone cement | 3.12 ± 0.20 * | 8.44 ± 0.31 * | 42.37 ± 7.46 * |
| Samples | Surface Area (m2/g) | Pore Volume (cm3/g) | Pore Size (nm) |
|---|---|---|---|
| Genta-free mMBG | 187.60 | 0.45 | 9.54 |
| 2Genta@mMBG | 274.45 | 0.59 | 8.57 |
Publisher’s Note: MDPI stays neutral with regard to jurisdictional claims in published maps and institutional affiliations. |
© 2022 by the authors. Licensee MDPI, Basel, Switzerland. This article is an open access article distributed under the terms and conditions of the Creative Commons Attribution (CC BY) license (https://creativecommons.org/licenses/by/4.0/).
Share and Cite
Hu, M.-H.; Chu, P.-Y.; Huang, S.-M.; Shih, B.-S.; Ko, C.-L.; Hu, J.-J.; Chen, W.-C. Injectability, Processability, Drug Loading, and Antibacterial Activity of Gentamicin-Impregnated Mesoporous Bioactive Glass Composite Calcium Phosphate Bone Cement In Vitro. Biomimetics 2022, 7, 121. https://doi.org/10.3390/biomimetics7030121
Hu M-H, Chu P-Y, Huang S-M, Shih B-S, Ko C-L, Hu J-J, Chen W-C. Injectability, Processability, Drug Loading, and Antibacterial Activity of Gentamicin-Impregnated Mesoporous Bioactive Glass Composite Calcium Phosphate Bone Cement In Vitro. Biomimetics. 2022; 7(3):121. https://doi.org/10.3390/biomimetics7030121
Chicago/Turabian StyleHu, Ming-Hsien, Pei-Yi Chu, Ssu-Meng Huang, Bo-Sin Shih, Chia-Ling Ko, Jin-Jia Hu, and Wen-Cheng Chen. 2022. "Injectability, Processability, Drug Loading, and Antibacterial Activity of Gentamicin-Impregnated Mesoporous Bioactive Glass Composite Calcium Phosphate Bone Cement In Vitro" Biomimetics 7, no. 3: 121. https://doi.org/10.3390/biomimetics7030121
APA StyleHu, M.-H., Chu, P.-Y., Huang, S.-M., Shih, B.-S., Ko, C.-L., Hu, J.-J., & Chen, W.-C. (2022). Injectability, Processability, Drug Loading, and Antibacterial Activity of Gentamicin-Impregnated Mesoporous Bioactive Glass Composite Calcium Phosphate Bone Cement In Vitro. Biomimetics, 7(3), 121. https://doi.org/10.3390/biomimetics7030121

